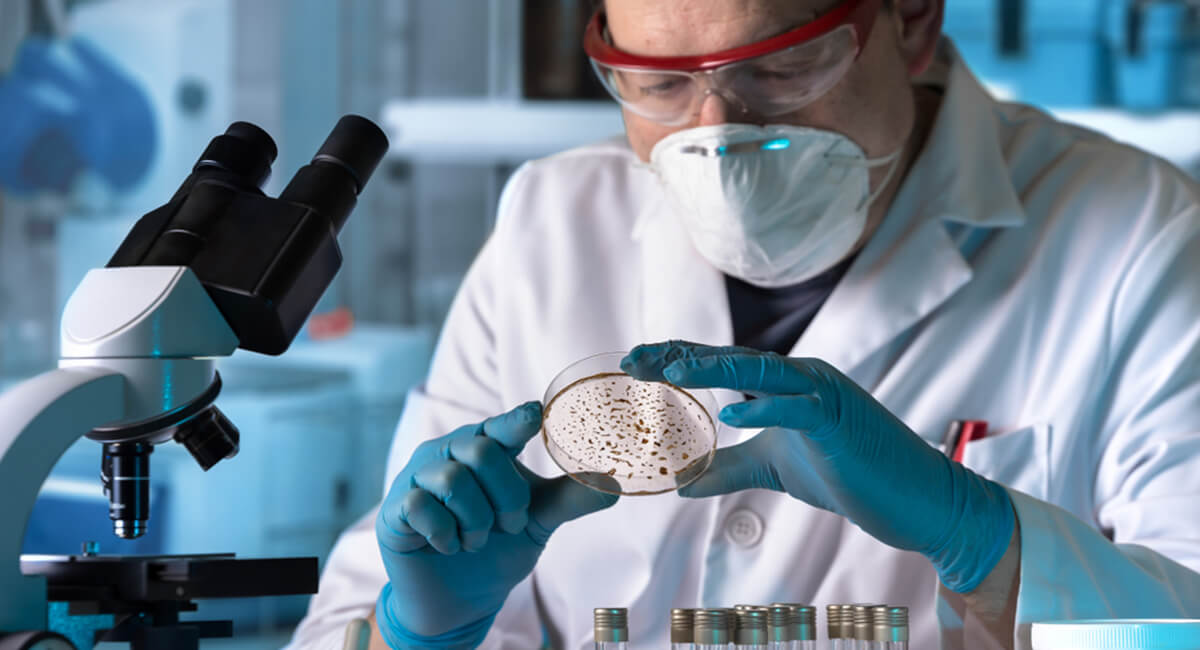
Foto de: Curso internacional en el proceso analítico en microbiología clínica

🥇 Datos generales
La microbiología clínica es una ciencia que identifica el microorganismo causante de las distintas infecciones que ocurren en el organismo y determina la sensibilidad que pueden presentar a los antibióticos o antifúngicos. Se trata de una ciencia biológica muy importante, ya que los microorganismos están presentes en todos los ecosistemas.
Por eso, se trata de una ciencia que también responde a las necesidades clínicas del médico, ya que tiene el objetivo de identificar el agente etiológico de una infección y, con ello, es posible establecer un diagnóstico y tratamiento adecuado. Generalmente, estos estudios se realizan en laboratorios clínicos con el proceso analítico.
Este programa formativo contiene material teórico y práctico con el que el alumno conocerá las novedades tecnológicas y científicas relacionadas con la microbiología. De esta forma, entre otras cosas, también actualizará sus conocimientos referentes a la bacteriología derivada de la recogida, análisis y procesamiento de muestras.
✔️ Requisitos de acceso
- Copia del DNI, TIE o Pasaporte.
📆 Plazo inscripción
La inscripción en esta actividad online permanecerá abierta hasta final de edición.
📝 Evaluación
La evaluación estará compuesta:
- 31 Preguntas tipo test.
- 5 Supuestos prácticos.
En caso de no superar el total de las evaluaciones conjuntamente, el alumno dispone de una segunda oportunidad sin coste adicional.
🎓 Destinatarios
A quién está dirigido el Curso internacional en el proceso analítico en microbiología clínica
Este programa formativo online / a distancia esta dirigido a todo aquel personal de:
- Licenciados/as o graduados/as en farmacia.
- Biólogos en ciencias de la salud.
- Bioquímica.
- Técnicos superiores de laboratorio clínico y biomédico.
🎯 Objetivos
Objetivos generales
-
Mejorar las actuaciones clínicas de los profesionales implicados en el procesamiento y análisis en microbiología clínica, aportando una base de conocimientos suficientemente amplios, actualizados y sobre todo útiles.
- Establecer las novedades tecnológicas y científicas relativas a microbiología y todos los procesos y consideraciones bioquímicas actuales.
Objetivos específicos
- Adquirir los conocimientos y herramientas para llevar a cabo investigaciones en la materia, creando así nueva evidencia empírica.
- Revisar una serie de conceptos microbiológicos implicados en la eficacia de los tratamientos con agentes antibacterianos, así como definir y comentar algunos parámetros mixtos denominados índices de eficacia que se utilizan para optimizar la misma.
- Actualizar las novedades tecnológicas y científicas, los conocimientos referentes a la bacteriología derivada desde la recogida, análisis y procesamiento de muestras en relación con la interpretación técnica y diagnóstica, ofreciendo un programa de interacción dinámica que acerque a la práctica clínica los conocimientos sobre microbiología clínica.
- Conseguir una actuación de calidad basada en protocolos y guías de práctica clínica actualizadas, procurando así la excelencia a nuestro quehacer diario.
- Impulsar la práctica de las guías de práctica clínica basadas en la evidencia para el procesamiento integral de muestras en el laboratorio hospitalario.
Plan de estudios
Tema I. Microbiología clínica:
- Conceptos generales en microbiología.
- Características de la microbiología.
- Metabolismo bacteriano.
- Taxonomía bacteriana.
- Identificación bacteriana.
- Microorganismos implicados en procesos infecciosos. Bacterias.
- Cocos Gram +.
- Cocos Gram -.
- Género Neisseria.
- Género Brucella.
- Otras bacterias intracelulares.
- Bacilos Gram +.
- Bacilos Gram -.
- Pruebas microbiológicas.
- Coprocultivo.
- Exudado vaginal.
- Exudado endocervical.
- Exudados uretrales.
- Enfermedades de transmisión sexual.
- Gonorrea.
- Chlamidia.
- Sífilis (Treponema pallidum).
- Herpes (virus herpes simple tipo 1 y 2, VHS).
- Verrugas genitales/PVH (papilomavirus humano - PVH).
- Infección por VIH, SIDA.
- Hepatitis B.
- Hepatitis A.
- Vaginitis (Tricomonas).
- Exudados conjuntivales.
- Raspados corneales.
- Exudados óticos.
- Exudado faríngeo y nasofaríngeo.
- Exudado faríngeo.
- Cavidad orofaríngea.
- Senos paranasales.
- Exudado nasal.
- Técnicas generales en microbiología.
- Medios de cultivo y preparación.
- Condiciones generales para el cultivo de microorganismos.
- Hemocultivos.
- Técnicas de siembra de muestras biológicas.
- Técnicas de tinción en microbiología.
- Tinción de Gram.
- Tinción con rodamina-auramina y con naranja de acridina.
- Tinción de Ziehl-Neelsen (Baar).
- Tinción con blanco de calcoflúor.
- Pruebas de sensibilidad. Antibiograma.
- Antibióticos.
- Pruebas de sensibilidad.
- Antibiograma.
- Medios de cultivo y preparación.
- Resumen.
- Autoevaluación.
- Bibliografía.
Sobre los Profesores

Rafael Ceballos Atienza
Tutor de esta Formación
Doctor en Medicina y Cirugía por la Universidad de Granada (España).

Sonia Baeza García
Tutora de esta Formación
Graduada en Psicología por la Universidad de Granada (España) y Técnico Superior en Salud Ambiental.

Juan Ramón Ledesma Sola
Tutor de esta Formación
Técnico Auxiliar en cuidados de enfermería.

Inmaculada Gonzalez Funes
Tutora de esta Formación
Graduada en Enfermería por la Universidad de Jaén (España).